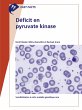
Fast Facts: Déficit en pyruvate kinase... - Bild 1

Fast Facts: Déficit en pyruvate kinase (eBook, ePUB)
Sensibilisation à cette maladie génétique rare
Versandkostenfrei!
Sofort per Download lieferbar
0,00 €
inkl. MwSt.
Weitere Ausgaben:

PAYBACK Punkte
0 °P sammeln!
Vous ne connaissez peut-être pas le déficit en pyruvate kinase (PK). C'est une maladie enzymatique héréditaire rare qui affecte la glycolyse utilisée par les globules rouges pour fabriquer de l'énergie. Elle se manifeste par une anémie hémolytique. Les symptômes varient énormément d'un individu à l'autre, ce qui rend le diagnostic difficile. Et la gestion de cette maladie consiste essentiellement en des traitements de soutien. Rédigé par des experts dans le domaine, 'Fast Facts : Déficit en pyruvate kinase' fournit une introduction complète de la maladie et donne des détails s...
Vous ne connaissez peut-être pas le déficit en pyruvate kinase (PK). C'est une maladie enzymatique héréditaire rare qui affecte la glycolyse utilisée par les globules rouges pour fabriquer de l'énergie. Elle se manifeste par une anémie hémolytique. Les symptômes varient énormément d'un individu à l'autre, ce qui rend le diagnostic difficile. Et la gestion de cette maladie consiste essentiellement en des traitements de soutien. Rédigé par des experts dans le domaine, 'Fast Facts : Déficit en pyruvate kinase' fournit une introduction complète de la maladie et donne des détails sur : . l'anomalie sous-jacente . son mode de transmission et la relation entre le génotype et le phénotype . la manière dont la maladie se manifeste . les fondamentaux du diagnostic et la manière de différencier la maladie d'un groupe hétérogène d'anomalies hémolytiques . la surveillance et la gestion des complications qui peuvent se produire. 'Fast Facts : Déficit en pyruvate kinase' sera d'un intérêt essentiel pour les professionnels de santé, les hématologues, les oncologues, les pédiatres, les spécialistes en médecine interne, les infirmiers en hématologie et les étudiants en médecine... en fait à tous ceux qui souhaitent en savoir plus sur cette anomalie génétique rare.
Dieser Download kann aus rechtlichen Gründen nur mit Rechnungsadresse in A, D ausgeliefert werden.